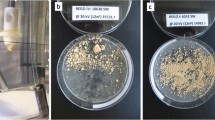

Abstract
The objective of this study is to reveal the potential of micro scale hydrodynamic bubbly cavitation for the use of kidney stone treatment. Hydrodynamically generated cavitating bubbles were targeted to the surfaces of 18 kidney stone samples made of calcium oxalate, and their destructive effects were exploited in order to remove kidney stones in in vitro experiments. Phosphate buffered saline (PBS) solution was used as the working fluid under bubbly cavitating conditions in a 0.75 cm long micro probe of 147 μm inner diameter at 9790 kPa pressure. The surface of calcium oxalate type kidney stones were exposed to bubbly cavitation at room temperature for 5 to 30 min. The eroded kidney stones were visually analyzed with a high speed CCD camera and using SEM (scanning electron microscopy) techniques. The experiments showed that at a cavitation number of 0.017, hydrodynamic bubbly cavitation device could successfully erode stones with an erosion rate of 0.31 mg/min. It was also observed that the targeted application of the erosion with micro scale hydrodynamic cavitation may even cause the fracture of the kidney stones within a short time of 30 min. The proposed treatment method has proven to be an efficient instrument for destroying kidney stones.
Similar content being viewed by others
Avoid common mistakes on your manuscript.
Introduction
Hydrodynamic cavitation is the formation of gas bubbles in a liquid region due to a sudden pressure drop of the liquid below its vapor pressure. This pressure drop leads to vaporization and bubble generation even at room temperatures. When successfully targeted on desired surfaces, the cavitation bubbles collapse upon subjection to atmospheric pressure. This process leads to the emergence of energetic shock waves that are highly destructive and might cause significant damage on exposed surfaces.5
Cavitation erosion is caused by the repetitive impingement of cavitation-induced bubbles on a solid flow boundary.5 Most of the early observations of cavitation damage were made on machines, such as ships’ propellers and hydraulic turbines, which operated in a liquid medium.8 The same damaging effects of collapsing bubbles have been exploited as a tool in kidney stone therapy, namely, surgery, and lithotripsy.2
Kidney stone disease is a very common health problem. Approximately 5% of women and 10% of men suffer from kidney stone formation at least once in their lives.6,21 Urinary stones may be the result of genetic predisposition, due to some abnormalities of kidney anatomy (e.g., horseshoe kidney), chronic and/or metabolic abnormalities (e.g., renal tubular acidosis), medication, diet-related or secondary infections. They might be the cause of discomfort, pain, and bleeding and lead to serious complications such as kidney dysfunction or difficult to cure infections. For that reason, most of the stones need to be removed. In addition to drug treatment and dietery restrictions, the common treatment for stone disease is open surgery, retrograde or percutaneous antegrade endoscopic surgery or shock wave lithotripsy. The latter is a popular approach to treat kidney stones in selected cases, by their destruction into small pieces using sound waves, so that they can more easily pass into the bladder and eventually discarded or extracted.18 However, the procedure is associated with pain or discomfort.10–12,15 For this reason, light anesthesia or sedation are required to minimize these effects and increase the patient’s comfort. As other side effects, the patient might experience blood in the urine, internal bleeding, pain as the smaller stone particles pass through the ureters and urethra and skin bruising, particularly on the back or abdomen.10,15 Moreover, the technique may be commonly implemented only for stones located in the kidney and for those <1–2 cm in size. Repetitive or multi-session applications of this technique are necessary for larger or multiple stones.
Depending on the etiology, chemical composition of stones is various. A majority of kidney stones are calcium based ones, with calcium oxalate (CaOx) and calcium phosphate (CaP) accounting for approximately 80% of all of those stones, while uric acid (UA) accounts for approximately 9%, and struvite (magnesium ammonium phosphate hexahydrate) has a percentage of 10%.9 Calcium-based stones including calcium Oxalate (CaOx) stones are especially hard and their physico-chemical properties impose a greater difficulty for the application of shock wave lithotripsy,4 which is generally suitable for softer stones such as uric acid stones.
Kidney stones are common health problems and a significant share of health expenses in any year is spent in their treatment. Therefore, cost effective and innovative methods of treatment should be explored. We have previously introduced the potential of hydrodynamic cavitation for the use in biomedical therapy, and evaluated its destructive effects on cancer cells.14 In the same study, original experiments were conducted on chalk as a model of kidney stones. Effective erosion on the specimen’s surface in this study has proven the future implementation of the method on natural kidney stones from patients. As an extension of our previous work, here we explored the effect of hydrodynamic cavitation on CaOx based kidney stones obtained from 18 patients. We assessed the capability and applicability of the hydrodynamic cavitation method for kidney stone treatment and compared the proposed therapeutic application to the existing methods (e.g., ultrasound treatment). Our study introduces for the first time hydrodynamic cavitation as an alternative and effective kidney stone destruction method.
Materials and Methods
Hydrodynamic cavitation is the phenomenon, where inception, growth, and implosion of cavities are successively triggered in the body of a flowing liquid due to sudden changes in the fluid pressure. If a liquid flowing in a channel with a specific flow rate is forced through an orifice throat (Fig. 1a), the fluid velocity increases due to mass conservation. As the fluid velocity increases in a short microchannel (micro orifice), the pressure of the fluid decreases dramatically following the Bernoulli Equation. This decrease leads to sudden vaporization and formation of gas bubbles in the liquid at room temperature. The exit of the orifice could be subjected to ambient pressure, and emerging bubbly cavitating flow could be targeted onto the specimen. At that stage, the cavitation bubbles self-destruct and collapse inward. During the final stages of bubble implosion, the bubble wall velocity can reach or exceed the liquid speed of sound and shock waves are produced in the liquid.1,2,5 These destructive effects can be exploited when applied on solid surfaces and lead to erosion on them.
The schematic of the experimental setup for generating bubbly cavitating flows is shown in Fig. 1b. A pressure driven flow follows the path in the schematic. When the fluid passes through a short micro probe, low pressures inside the microprobe are reached leading to formation of micro bubbles.2 The micro bubbles emerging from the exit of the micro probe are targeted on various kidney stone samples. Hydrodynamic cavitation and emerging bubble motions are captured by Phantom v320 high speed camera.
This experimental setup is composed of a compressed air tank with controlled valve, pressure gauge with 6.8 kPa sensitivity, tubing, a high pressure Omega turbine flow meter with 0.011 mL/s sensitivity, and a fine control valve. Bubbly cavitating flows are generated using micro orifice geometry with a 0.75 cm long micro probe of 147 μm inner diameter. Orifice geometry was fabricated by laser drilling polyether ether ketone (PEEK) tubes to obtain the desired inner diameters for the biomedical applications. PEEK material is a semi crystalline thermoplastic with good mechanical and chemical resistance properties up to high temperatures. The material has great corrosion resistance and suitable for medical applications, which require sterile environment.19
Before the experiments, kidney stone samples were surgically removed in Demetevler Oncology Hospital, Ankara, and kept in saline solution at room temperature until experimentation. Surgically acquired kidney stones, which were taken from the same kidney, were classified according to their sizes. Similar stones have been selected to be analyzed by XRD (X-Ray Diffraction). Accordingly, XRD analyses of the 18 kidney stone specimens have shown that all the stones are composed of 90% calcium oxalate and 10% phosphate, whose material properties are included in Table 1.
The experimental parameters have been adjusted in a controllable way to maintain effective hydrodynamic cavitation intensity (cavitation number σ ~ 0.017). Kidney stone sample to be tested was stabilized to a holder, and soft tape is placed between the kidney stone and the holder in order to avoid any disturbance on the specimen. Inlet pressures were adjusted to make sure to generate bubbly cavitating flow patterns at the desired intensity for destructive effects, while outlet pressure remained constant at atmospheric pressure. Effective penetration depth caused by cavitating flows and the resulting destructive effect were highly dependent on the distance between the micro probe and the specimen (Fig. 1c). 1 mm probe gap was selected as an optimal distance in the tests on kidney stone in parallel lines to our previous study.14 Cavitation intensity is highly dependent on the probe inner diameter, pressure and probe gap. We intended to use 147 μm inner diameter probe, which is suitable for both cavitation inception at moderate inlet pressures and visualization with the existing equipment. Small size of the probe provides more localized treatment. The diameter of the probe is selected to obtain the desired bubble size while the spacing between the probe and the specimen is determined in order to enhance bubble–specimen interaction and by taking the micro manipulator specifications into account.
The sterile conditions were sustained by autoclaving all the probes, orifice throat, containers, and valves before each test. Chemically and physically similar kidney stones were utilized for the cavitation experiments. The weight of each kidney stone specimen (listed in Table 2 with exposure durations) was measured before and after the experiments with 0.1 mg sensitivity.
After each test, eroded kidney stones were placed to a sterile container kept at room temperature and were left to dry for a day. Thereafter, the weights of the specimens were measured again so that erosion amounts could be assessed.
For assessing the erosional effects caused by hydrodynamic cavitation on kidney stones control experiments were performed. The control experiments were conducted with a probe having a larger inner diameter (2.8 mm). In these experiments, the same outlet velocities for both cavitating and non cavitating conditions were first considered. For a small amount of time (around 2 min), no significant erosional change was observed in control experiments with the same outlet velocity. However, because of the limitations of experimental setup, it was not possible to the use same velocity for longer times. Instead, the flow rate value was fixed to maintain comparable results for the real and control experiments. Because of this limitation, the flow rate was kept as the same (1.9 mL/s) as under non-cavitating flow conditions and the experiments were conducted for each time value. The obtained results were recorded and compared to the cavitating conditions. It was observed that no significant erosion on kidney stone samples was present after the control experiments, which were conducted under non-cavitating conditions. Moreover, a similar experimental setup placing a kidney stone in a finger tip size container with 5 cc volume was prepared to compare freely rotating kidney stones with stationary stones during the application of bubbly cavitation. Freely moving stones were exposed to bubbly cavitation with the same intensity. Under these conditions, the initial and final weights of the samples were measured. The erosion on the rotating stones had the same linear trend as the stationary stones. Therefore, the change of the exposed area on the stone did not affect the total erosion amount on the exposed sample.
Results
Figure 2 displays flow rates as a function of inlet pressures. The flow rate has an increasing trend with inlet pressure as can be seen from this figure. At higher inlet pressures, the slope of the trend decreases indicating the arrival of choked flow conditions, which were also reported in the literature about hydrodynamic cavitation in micro scale.3 During the experiments, it was observed that cavitation incepted at a pressure of ~992 kPa. By increasing the pressure beyond this point more distinct bubble clouds were observed (Fig. 3). The emerging micro bubbles from the exit of the micro probe were recorded by the high speed camera, and the bubble sizes were measured using captured images. The size of the micro bubbles targeted to the samples varied from 60 to 300 μm.
The maximum pressure value was imposed by the maximum available pressure for the present experimental setup measured as 9790 kPa. Under the conditions of the maximum applied pressure, the flow rate was measured as 1.9 mL/s, while the corresponding cavitation number was deduced as σ ~ 0.017. This value lies within the range of the existing micro scale cavitation studies.16
The erosional effects of hydrodynamic cavitation have been assessed by comparing the initial weights of kidney stones to their final weights. Furthermore, the resulting kidney stone damage was also visually monitored. After the experiments, eroded kidney stones showed a more porous structure, and their volumes were visibly reduced. Their shape also became more spherical as shown in Fig. 4. Bubble-kidney stone interactions lead to a more regular and porous shape.
As can be seen from Figs. 5a, 5b, and 5c, a linear relation between erosion amount and time can be observed. If however the stone sample is broken during the experiment, the profile diverges from this linear trend (Stones 10, 11, 15, 17) as indicated with black circles. When the kidney stone sample breaks, almost two equivalent halves are formed along with many small particles (debris, Fig. 6), which can easily go through the urinary tract and were therefore not considered when measuring the final weight of the treated kidney stone sample. The total mass of the small particles and debris accounts for a significant portion of the final weight. Because this portion is not taken into account, a jump in the erosion amount and diversion from the linear trend occurs upon the fracture of kidney stone samples (Fig. 5).
In an attempt to develop a general prediction tool for the average erosion rate on calcium oxalate based kidney stones caused by hydrodynamic cavitation, Sheldon and Finnie’s 90° brittle erosion model17 recommended for brittle surface materials is utilized as the reference. In this model, erosion is considered as removal of surface material by the cumulative actions of individual particles. Calcium oxalate based kidney stones are brittle and thus cannot deform elastically. Instead, they crack and fracture when subjected to tensile stress. The angle of maximum erosion for brittle materials is close to 90°.5 Accordingly, erosion rate is expressed in this model for spherical particles, which are considered as micro bubbles in this study, as:
where R p is the particle radius (average bubble radius, 180 μm in this study), σb is the flexural strength, V is the particle velocity, and E t is the Young’s modulus of elasticity. Using the average erosion rate of 0.31 mg/min found in the results on erosion rates in this study and assuming that micro bubbles emerging from the microprobe have the same velocity as the flow velocity inside the microprobe, this model supplies a friction coefficient (f) value of 2.65. This value could be utilized as the input for Eq. (1) so that Eq. (1) could be employed to estimate the average erosion rate on calcium oxalate based kidney stones exposed to hydrodynamic cavitation leading to micro bubbles of size R p and flow velocities V at the microprobe cross section.
Despite the fractures in some kidney stone samples, the average erosion amount demonstrates a linear trend with time (Fig. 7). Accordingly, an average material removal rate of 0.31 mg/min is obtained from the experiments (Fig. 7a). It can also be seen that no significant change in the mass of kidney stone samples is apparent after the control experiments suggesting that major erosion was caused by bubbly cavitating flows rather than shear forces caused by pure fluid jet flows. The corresponding average changes in mass percentages for kidney stone samples are included in Fig. 7b. Erosion percentages up to 10% could be attained within half an hour with the proposed method. Moreover, 4 out of 18 kidney stones were broken within short time proving the effectiveness of the proposed method.
Discussion
The treatment duration for lithotripsy typically varies from 5 to 160 min20 and has an average of 30 min for the most treatment sessions. For the alternative technique of hydrodynamic cavitation considered in this study, above mentioned kidney stones were broken into pieces within a short time of 25–30 min, which has a significant overlap in the duration with the lithotripsy method. By optimizing the experimental conditions such as microprobe geometry, microprobe size, the distance between the kidney stone and microprobe and the use of multiple microprobes, significant improvement of the performance of the proposed technique could be attained. These promising results suggest that hydrodynamic cavitation in micro scale has a potential of being a strong alternative for ultrasound therapy. Ultrasound therapy offers the remote application advantage. However, using micro manipulator could provide fine control of the exposure of bubbly hydrodynamic cavitation on the target area so that localized therapy could be expected. For specified intensity of this study, it was observed in visualization studies that the emerging micro bubbles could reach a range of 2 mm. As a result, the probe to sample distance is selected as 1 mm to minimize potential damage on the surrounding tissue and to provide successful targeting. Concentrated efforts and future work on this area should yield a prototype that could have a highly targeted, localized, and controlled effect on kidney stones so that other areas in the vicinity will not be affected unwanted effects to the surrounding normal tissue will be minimized. This prototype could provide a cost effective and energy efficient solution for kidney stone therapy. It is expected that the prototype would have a manufacturing cost lower than $10,000. Taking administrative and marketing expenses into consideration, the unit price of the hydrodynamic cavitation device is expected to be in the competitive range with commercially available products based on lithotripsy.7
Surface characteristics of the tested kidney stone samples are carefully investigated by Scanning Electron Microscope (SEM) technique and a high resolution light microscope. Surface morphology before and after hydrodynamic cavitation exposure of the tested kidney stones are compared based on SEM images (Fig. 8). A significant difference in the stones’ surface has been observed in the form of a change in surface roughness compared to the unexposed surfaces. Accordingly, crystal-like surface structure of the kidney stone samples was “shaved off” after the micro-mechanical erosion generated by cavitating bubbly flows during the experiments. As can be observed, sharpness of the edges and corners are significantly reduced after the cavitation exposure. After each experiment, stone debris was analyzed under a light microscope. Maximum debris size is found to be around 110 μm (Fig. 8). Small debris size implies that there will be no difficulties for the debris to pass through the urinary tract.
The results from the experiments have shown that hydrodynamic cavitation could be used as a promising alternative to ultrasound therapy methods for kidney stone treatment. Micro scale hydrodynamic cavitation offers several advantages such as fine controllability, low power consumption, low heat generation, and successful targeting. It is more energy efficient and cost effective compared to the other methods, whereas the therapy duration also well overlaps with the therapy duration ranges for the other methods. Indeed, the diameter of the cavitation probe and the tubing is 1.56 mm, a size that can fit in a regular 5 mm endoscopy device. Its destructive effects were proven on kidney stones in this study. The working fluid (Phosphate buffered saline) used in the experiments is non-toxic and isotonic to the human body. Moreover, the liquid could be discharged from the body simultaneously during the application using a parallel discharge line, which could be integrated to the endoscopy device. Therefore, we believe that the proposed method is a practical option to be implemented in human body. However, further in vivo animal studies and clinical studies are needed for better understanding and characterization of the possible outcomes of the proposed method.
References
Brennen, C. E. Cavitation and Bubble Dynamics. London, UK: Oxford University Press, 1995.
Brennen, C. E. Fundamentals of Multiphase Flow. New York: Cambridge University Press, 2005.
Chong, X. Subsonic choked flow in the microchannel. Phys. Fluids 18:127104, 2006.
Coe, F. L., A. Evan, and E. Worcester. Kidney stone disease. J. Clin. Investig. 115:2598–2608, 2005.
Crowe, C. T. Multiphase Flow Handbook. Boca Raton, FL: CRC Press, 2006.
Dales, L. G., G. D. Friedman, E. M. Hunkeler, and R. A. Hiatt. Frequency of urolithiasis in a prepaid medical care program. Am. J. Epidemiol. 115:255–265, 1982.
DiSario, J., R. Chuttani, J. Croffie, et al. Flow visualization of cavitating flows through a rectangular slot micro-orifice ingrained in a microchannel. Gastrointest. Endosc. 65:750–756, 2007.
Eisenberg, P. Cavitation Damage, Hydronautics. Incorporated Washington, DC, AD No. 602833, 1963.
Evan, A. P. Physiopathology and etiology of stone formation in the kidney and the urinary tract. Pediatr. Nephrol. J. 25:831–841, 2010.
Evan, A. P., and J. A. McAteer. Q-effects of shock wave lithotripsy. In: Kidney Stones: Medical and Surgical Management, Chap. 23, edited by F. L. Coe, M. J. Favus, C. Y. C. Pak, J. H. Parks, and G. M. Preminger. Philadelphia: Lippincott-Raven, 1996, pp. 549–560.
Evan, A. P., and L. R. Willis. Extracorporeal shock wave lithotripsy: complications. In: Smith’s Textbook on Endourology, Chap. 41, edited by A. D. Smith, G. H. Badlani, D. H. Bagley, R. V. Clayman, and S. G. Docimo. Hamilton, ON: Decker, Inc., 2007, pp. 353–365.
Evan, A. P., L. R. Willis, J. E. Lingeman, et al. Renal trauma and the risk of long-term complications in shock wave lithotripsy. Nephron 78:1–8, 1998.
Heimbach, D., R. Munver, P. Zhong, J. Jacobs, A. Hesse, S. C. Mülles, and G. M. Preminger. Acoustic and mechanical properties of artificial stones in comparison to natural kidney stones. J. Urol. 164:537–544, 2000.
Koşar, A., M. Şeşen, O. Oral, Z. Itah, and D. Gozuacik. Bubbly cavitating flow generation and investigation of its erosional nature for biomedical applications. IEEE Trans. Biomed. Eng. 58:1337–1346, 2011.
McAteer, J. A., and A. P. Evan. The acute and long-term adverse effects of shock wave lithotripsy. Semin. Nephrol. 28:200, 2008.
Mishra, C., and Y. Peles. Flow visualization of cavitating flows through a rectangular slot micro-orifice ingrained in a microchannel. Phys. Fluids 17:113602–113615, 2005.
Sheldon, G. L., and L. Finnie. The mechanism of material removal in the erosive cutting of brittle materials. ASME J. Eng. Ind. 88B:393–400, 1966.
Singh, S. K., M. M. Agarwal, and S. Sharma. Medical therapy for calculus disease. Br. J. Urol. Int. 107:356–368, 2010.
Skim, S., K. J. Lee, and Y. Seo. Polyetheretherketone (PEEK) surface functionalization by low-energy ion-beam irradiation under a reactive O2 environment and its effect on the PEEK/Copper adhesives. Langmuir 20:157–163, 2004.
Tan, E. C., K. H. Tung, R. Kwok, and K. T. Foo. Percutaneous ultrasonic lithotripsy—its role in the management of renal and upper ureteric stones. Singap. Med. J. 30:45–47, 1989.
Wilson, D. M., W. M. O’Fallon, R. S. Malek, L. T. Kurland, and C. M. Johnson. Renal stone epidemiology: a 25-year study in Rochester, Minnesota. Kidney Int. J. 16:624–631, 1979.
Acknowledgments
This work was supported by Sabancı University Internal Grant for Research Program under Grant IACF09-00642 and TUBITAK (The Scientific and Technological Research Council of Turkey) Support Program for Scientific and Technological Research Projects Grant, 111M621. Devrim Gozuacik is a recipient of “EMBO” Strategical Development and Installation Grant. The authors would like to thank Prof. M. A. Gulgun (Sabanci University) and M. Tosun (Ecole Polytechnique Federale de Lausanne) for their help in analysis of kidney stones. They are also thankful to Prof. Hakkı Perk from Demetevler Oncology Hospital for providing kidney stone samples. Undergraduate and graduate student support from Faculty of Natural Sciences and Engineering of Sabancı University and equipment utilization support from Sabanci University Nanotechnology Research and Applications Center (SUNUM) is also gratefully appreciated.
Author information
Authors and Affiliations
Corresponding author
Additional information
Associate Editor Kerry Hourigan oversaw the review of this article.
Rights and permissions
About this article
Cite this article
Perk, O.Y., Şeşen, M., Gozuacik, D. et al. Kidney Stone Erosion by Micro Scale Hydrodynamic Cavitation and Consequent Kidney Stone Treatment. Ann Biomed Eng 40, 1895–1902 (2012). https://doi.org/10.1007/s10439-012-0559-7
Received:
Accepted:
Published:
Issue Date:
DOI: https://doi.org/10.1007/s10439-012-0559-7